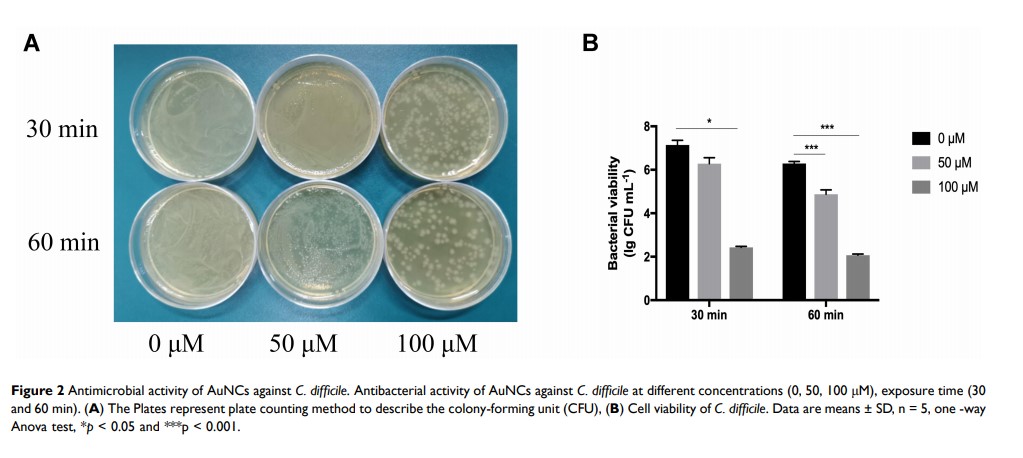

论文已发表
注册即可获取德孚的最新动态
IF 收录期刊
Original Research
肿瘤微环境响应的脂质体同时封装生物和化疗药物,以增强对非小细胞肺癌细胞(NSCLC)的抗肿瘤功效

Original Research
老药新用:埃索美拉唑减少单核吞噬细胞系统对纳米载体的吞噬

Original Research
氧化铈纳米颗粒通过调控活性氧簇的细胞生成来双向调节破骨细胞的分化

Original Research
制备可光交联的聚碳酸三亚甲基酯/聚己内酯纳米纤维支架,用于肌腱再生

Original Research
金纳米簇作为抗艰难梭菌的抗菌替代品
Original Research
开发和验证预后诺模图,以预测非 B 期、非 C 期肝细胞癌的长期预后
